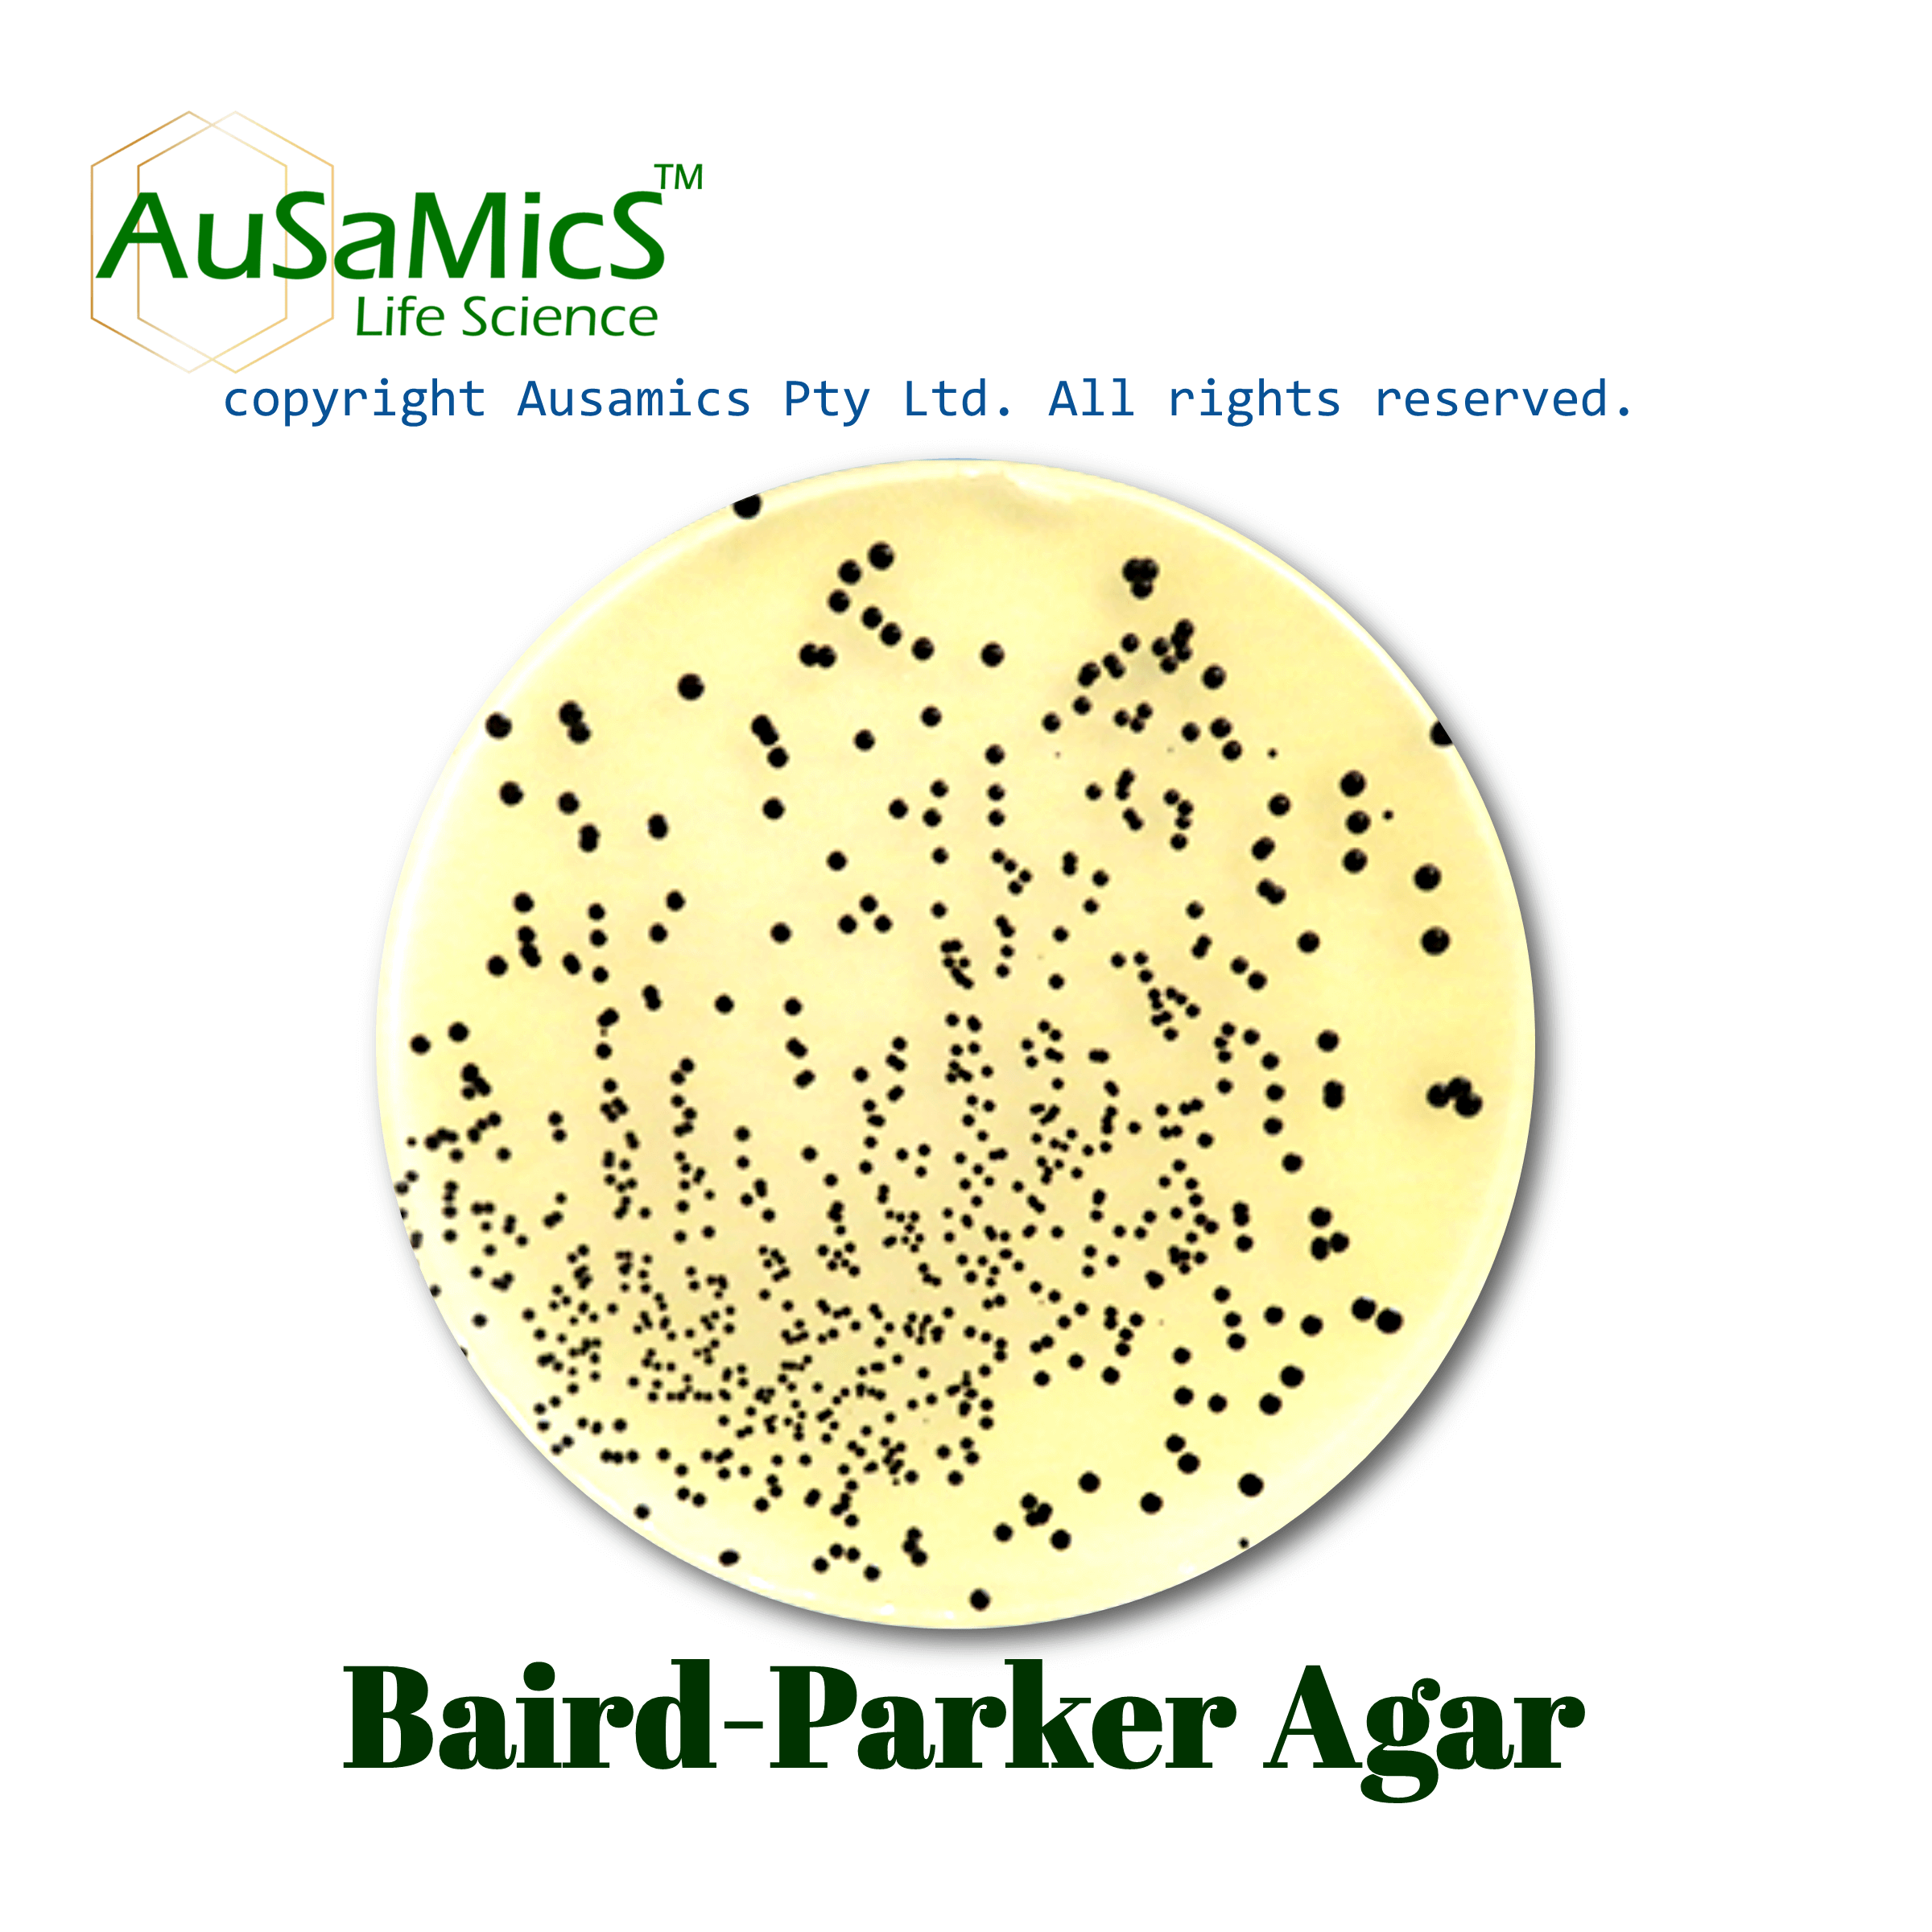
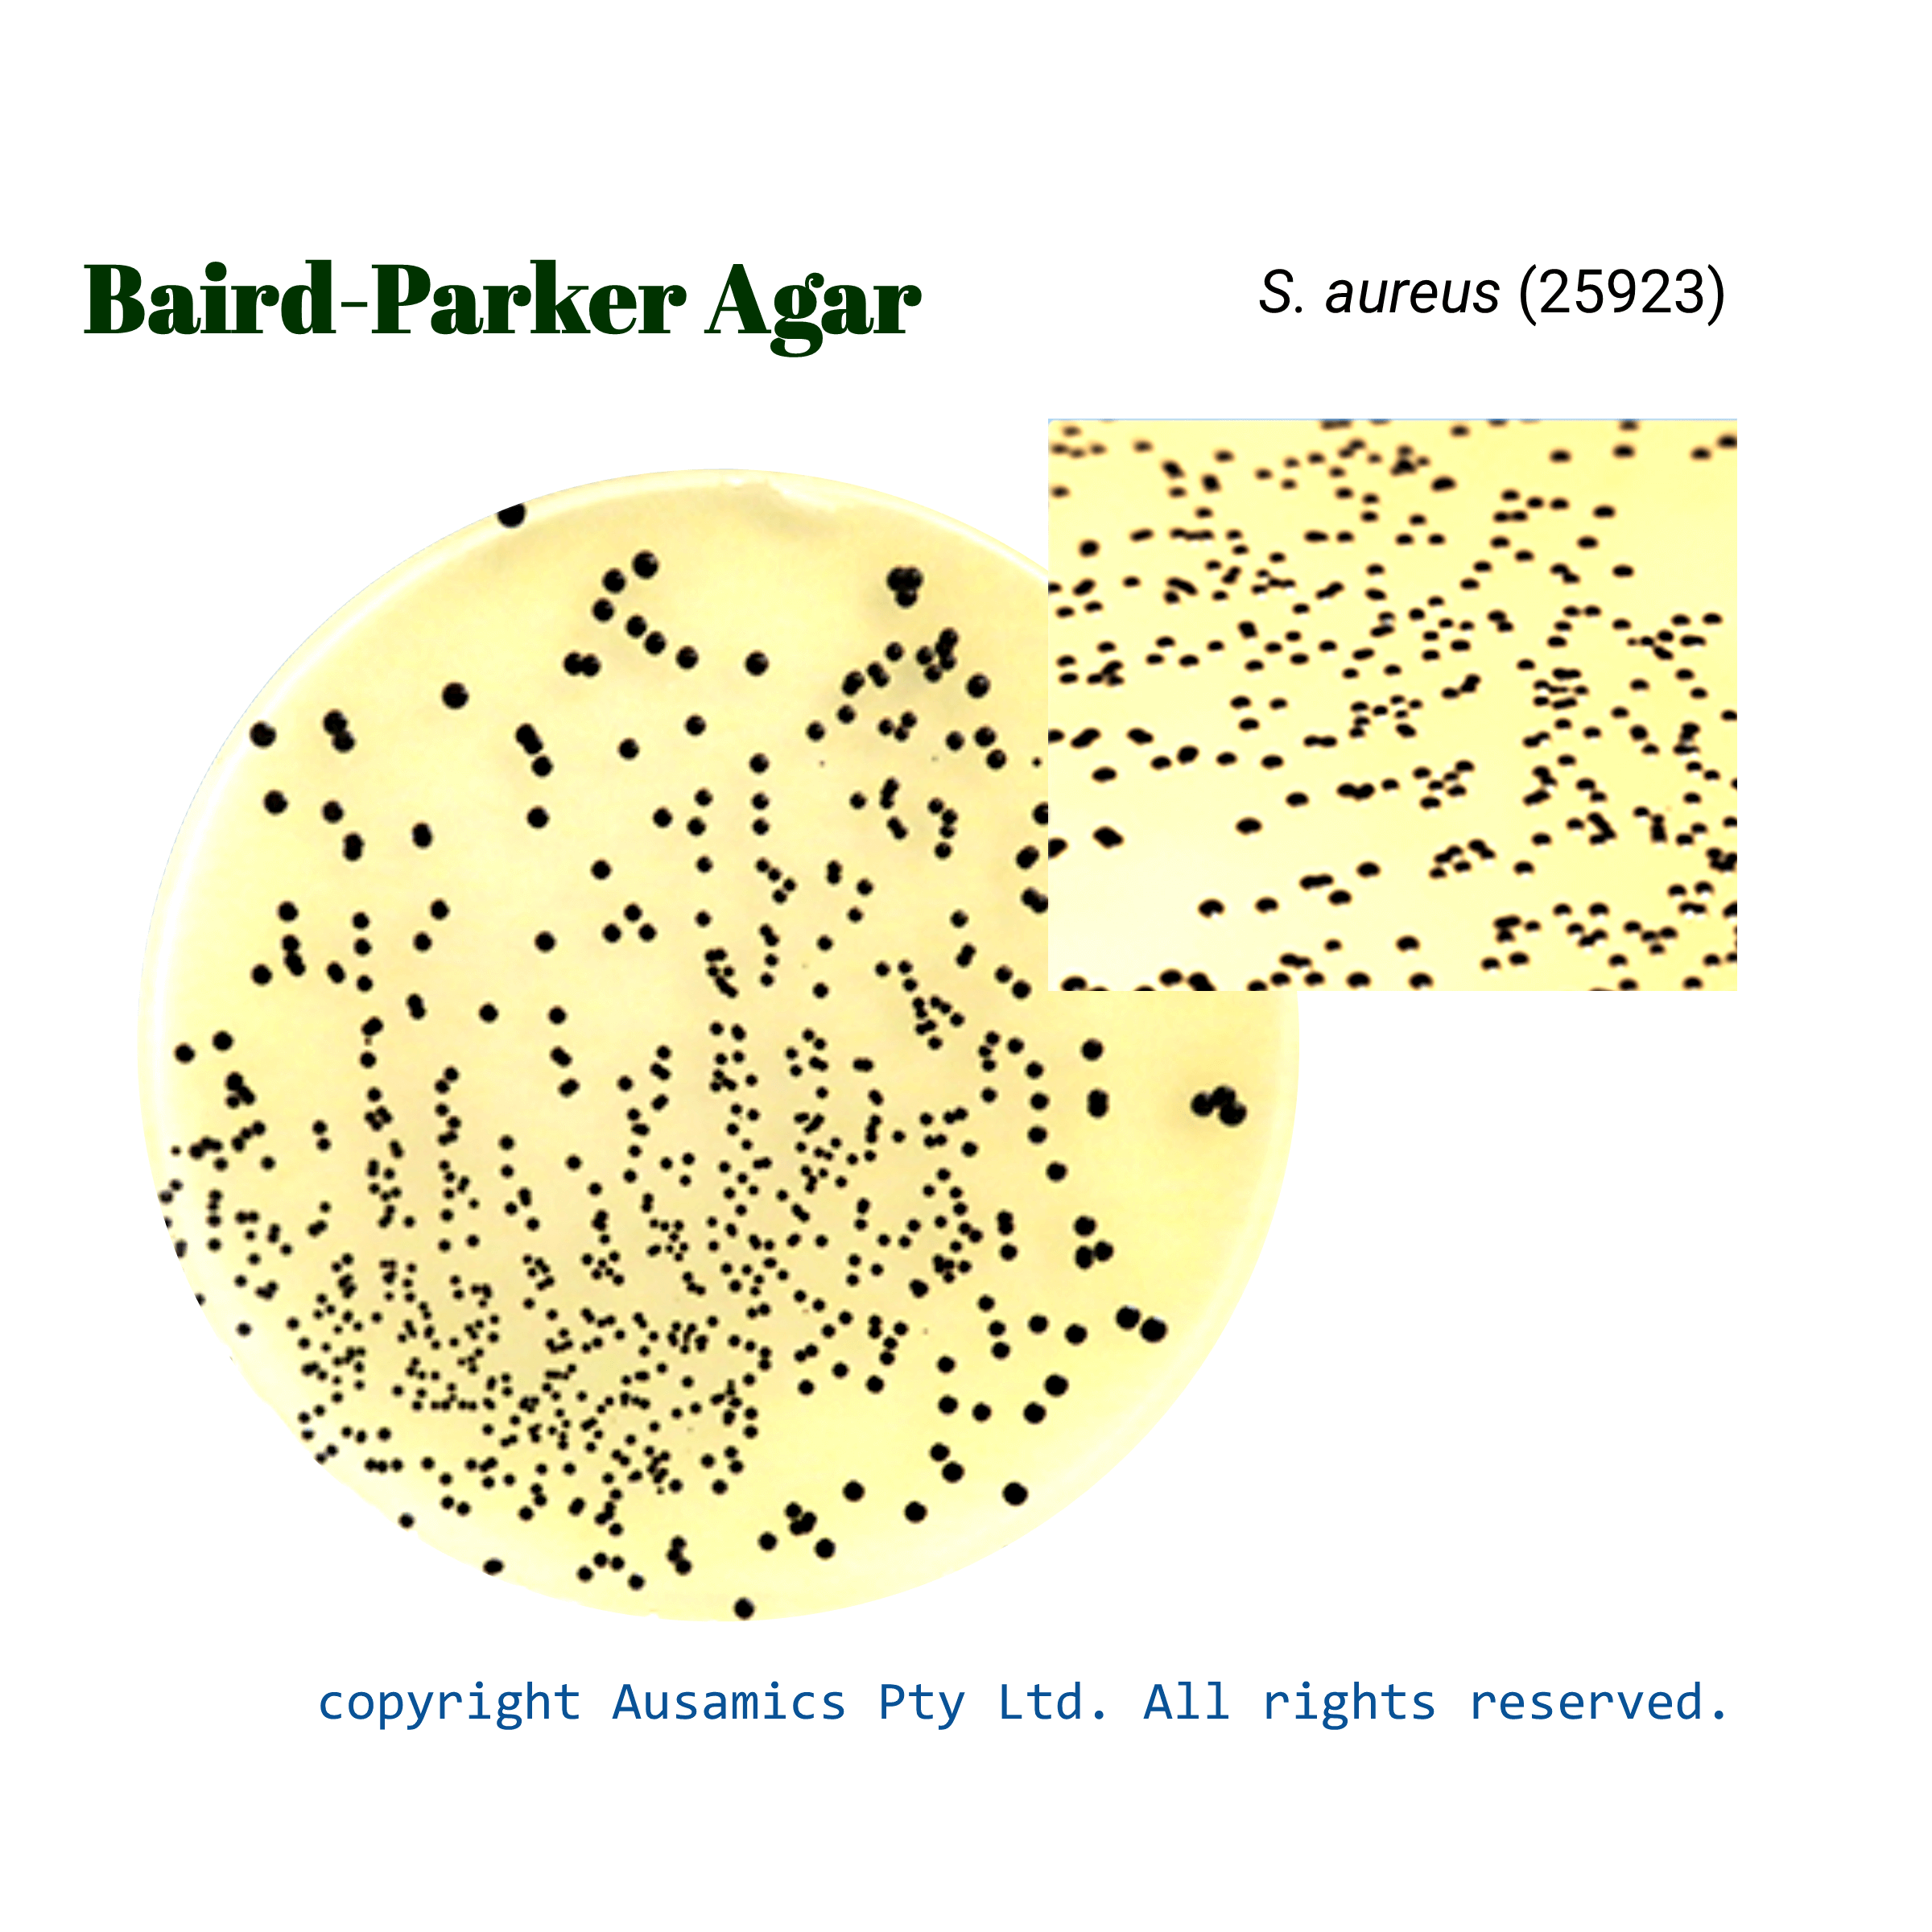

Baird-Parker Agar
Used to identify and count Staphylococcus aureus in food and medication materials.
- Description
- Composition
- Quality Control
- Microbial Test Results
Baird Parker Agar is a selective and differential medium primarily used for isolating and presumptively identifying coagulase-positive staphylococci, particularly Staphylococcus aureus, in food and pharmaceutical samples.
The medium’s base provides essential nutrients like nitrogen and vitamins through casein peptone, meat extract, and yeast extract. To inhibit competing microorganisms, lithium chloride and potassium tellurite are incorporated. Glycine and pyruvate enhance the growth of staphylococci.
The addition of egg yolk emulsion imparts differential characteristics. Coagulase-positive staphylococci exhibit characteristic grey to black colonies surrounded by a clear zone due to lipase activity and an opaque halo resulting from coagulase-mediated fibrinogen conversion to fibrin. This combination of colony morphology and halo formation is strongly indicative of coagulase positivity.
For definitive coagulase confirmation, Rabbit Plasma Fibrinogen can be incorporated into the medium. However, the presence of the opaque halo is often sufficient for presumptive identification. It’s important to note that while Baird Parker Agar effectively inhibits many contaminants, the addition of sulfamethazine can further suppress the growth of Proteus species.
Storage
Keep the container at 15-30 °C and prepared medium at 2-8 °C.
| Composition | gr/L |
| Pancreatic Digest of Casein | 10 |
| Beef Extract | 5 |
| Yeast Extract | 1 |
| Glycine | 12 |
| Sodium Pyruvate | 10 |
| Lithium Chloride | 5 |
| Agar | 15 |
| Final pH at 25°C | 6.8 ± 0.2 |
| Dehydrated Appearance | Light tan, free-flowing, homogeneous. |
| Prepared Appearance | Yellow, opaque. |
| Reaction of 5.8 % Solution at 25°C | pH 6.8 ± 0.2 |
| For 42 to 48 hours, incubate at 35 ± 2°C and read after 18-24 and 42-48 hours. | |||
| Organism (ATCC) | Recovery | Colony Color | Clear zones |
| Bacillus subtilis (6633) | None to poor | Brown | – |
| Staphylococcus aureus (25923) | Good | Black | + |
| Proteus mirabilis (25933) | Good | Brown | – |
| Escherichia coli (8739) | Inhibited | – | – |